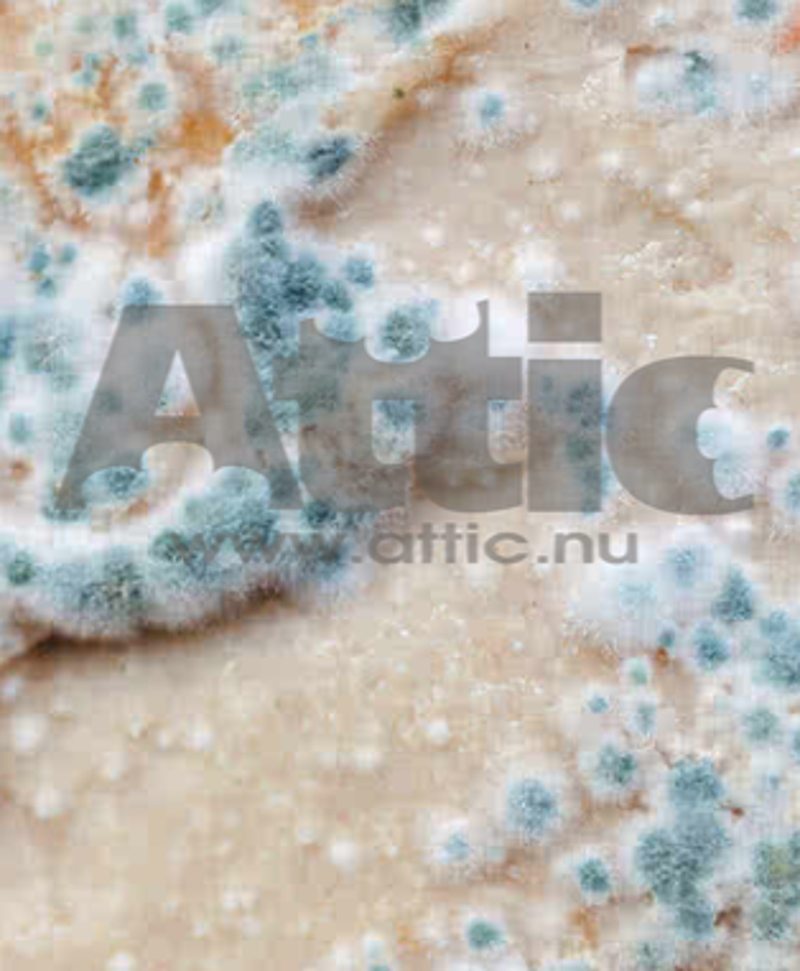

Het ontstaan van een zwam begint met sporen die ontkiemen. De daaruit ontsproten dunne draden (hyfen) vormen het schimmelweefsel (mycelium). Bij sommige soorten bundelen de hyfen zich tot strengen (rhizomorfen), die vocht en voedsel kunnen transporteren over grotere afstanden. Het schimmelweefsel is een ongeslachtelijk voortplantingsorgaan. Wil de zwam zich voortplanten dan vormt hij een vruchtlichaam dat op zijn beurt miljarden sporen produceert. Omdat sporen zeer licht en microscopisch klein zijn, worden ze veelal vervoerd door de luchtstromingen maar ook door insecten, (huis)dieren, de mens en zelfs water.
Verwarring tussen een schimmel en een zwam is eenvoudig: wanneer zich uit het mycelium een vruchtlichaam ontwikkelt dat met het oog herkenbaar is, spreken we van een ’zwam’.
Nu we weten of het een zwam of een schimmel betreft, kunnen we verder specificeren:
Groep 1

omvat schimmels en zwammen die het hout niet structureel aantasten, maar wel wijzen op gunstig milieu en een goede voedingsbodem voor de ontwikkeling van (schadelijke) zwammen eventueel bij andere omstandigheden. (uitdrogen van voedingsbodem, ...)
Voorbeelden; oppervlakteschimmels (vooral Penicillium spp., Aspergillus spp. en Cladosporium spp.) en zwammen zoals de inkt- en de bekerzwam (Coprinus spp. en Pezizaspp.). Deze laatste ontwikkelen een paddestoelvormig of bekervormig vruchtlichaam dat vrij groot is en gemakkelijk waargenomen kan worden.
Aangezien oppervlakteschimmels als voedingsbodem zelfs genoeg hebben aan huisstof kunnen ze op vrijwel elke ondergrond voorkomen, gaande van bepleisterde muren, behangpapier en hout tot steen en glas. Ze breken de ondergrond waarop ze leven echter niet af.
Oppervlakteschimmels hebben voor hun ontwikkeling niet veel meer nodig dan een plekje waar de verluchting enigszins te wensen overlaat, waardoor er een vochtig oppervlak ontstaat. Typisch zijn bijvoorbeeld aantastingen op de binnenzijde van kasten of de onderzijde van tafels. Oppervlakteschimmels lijken vaak witte pluisjes maar ze kunnen ook poederachtig zijn. Het kleurenpalet varieert van geel, roos, groen, grijs tot bruin en zwart. Meubels worden vaak geteisterd door witte pluisjes. De meeste schimmels veroorzaken enkel een oppervlakkige (weg te borstelen) verkleuring.
Groep 2


groep 2 omvat de zwammen die het hout niet afbreken maar voor een blijvende verkleuring zorgen, bijvoorbeeld de blauwschimmels (Aureo- basidium pullulans).De kleurstoffen van blauwschimmels dringen dieper door in het hout, wat het een blijvende grijsblauwe verkleuring geeft. De schimmels richten echter geen structurele schade aan.
Groep 3
dit zijn de houtafbrekende zwammen en deze zijn zoals je kan vermoeden zeer schadelijk.. De meest voorkomende zwam in deze categorie (althans in gebouwen en constructies) zijn de bruinrotters huiszwam (Serpula lacrymans), de kelderzwam (Coniophora puteana – Coniophora marmorata), de poriënzwam (Antrodia spp. en Oligoporus placenta) en tot slot de plaatjeshoutzwam (Gloeophyllum spp.). - de witrotters de bruine eikenzwam (Donkioporia expansa) en zachtrot De verschillende zwammen hebben hun eigen morfologische kenmerken en vertonen andere schadebeelden.
bruinrot: afbraak met kubische krimpscheuren en bruinverkleuring, diep in het hout indringend (kubisch rot of bruinrot) - witrot of vezelrot: afbraak waarbij een vezelige structuur ontstaat en het hout wit kleurt (vezelig rot of witrot); - zachtrot of natrot: oppervlakkige verwering van hout met een kubisch schadepatroon dat oppervlakkig blijft (zachtrot of natrot).

Klik hiernaast en selecteer erna indien en welke dienst-verlening u wenst ...

